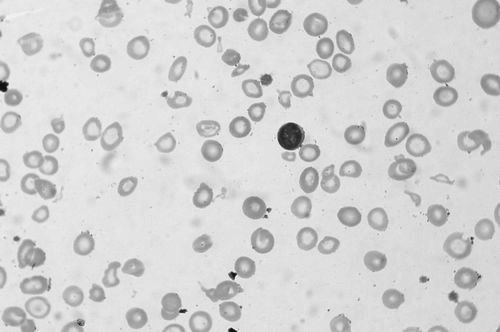

Анемія або недокрів'я, - це серйозне порушення роботи кровотворної системи, обумовлене зниженням концентрації гемоглобіну, гемокріта або кількості еритроцитів.
Залежно від причини анемії існують різні типи цього захворювання: анемія пов'язана з дефіцитом заліза, фолієвої кислоти або вітаміну В12, гемолітична анемія та апластична анемія. Довго не леченная анемія може привести до дуже серйозних порушень в роботі організму.
Наслідки анемії, викликаної дефіцитом заліза
Явна залізодефіцитна анемія в мазку периферичної крові
дефіцит заліза до розкриття симптомів анемії, викликаної дефіцитом заліза, називається сидеропенії. Симптоми цього типу анемії включають в себе зміни на шкірі, а також загальні симптоми. З'являються заїди в кутах рота. розтріскування плитки нігтя, ламкість волосся і нігтів, сухість шкіри. Доходить до появи симптомів синдрому Плуммера-Вінсона - атрофія слизових оболонок, язика, глотки і стравоходу, дисфагія (біль і відчуття печіння при ковтанні).
Загальні симптоми анемії - це блідість шкіри і слизових оболонок, слабкість, задишка, шум у серці, а також ослаблення концентрації уваги і головні болі. Якщо не лікувати залізодефіцитну анемію, то вона викликає психічні та неврологічні розлади, які включають в себе, перш за все, головні болі, дратівливість, синдром -беспокойних ніг-, характерні смакові бажання, наприклад, на землю або кальцій.
Наслідки мегалобластична анемії
мегалобластична анемія виникає через дефіцит вітаміну В12 або фолієвої кислоти. Зниження рівня фолієвої кислоти небезпечно, перш за все, у жінок в період вагітності. Тоді збільшується ризик пошкодження нервової системи плоду.
Симптоми анемії, викликаної дефіцитом вітаміну В12 характеризується співіснування тріади порушень: гематологічних, неврологічних і гастроентерологічних. Симптоми анемії через відсутність фолієвої кислоти схожі, але без розладів нервової системи.
Гематологічні порушення - це загальні симптоми анемії, а точніше, втома, зниження працездатності, блідість. Відсутності лікування анемії викликає поява світло-жовтого забарвлення шкіри. Симптоми шлунково-кишкового тракту включають трофічні зміни слизових оболонок, запалення язика (згладжування, почервоніння і печіння). Тривало не лікування недокрів'я від нестачі вітаміну В12 призводить до появи неврологічних симптомів. З'являються ознаки полінейропатії з хворобливими парестезиями рук і ніг. Одним з перших симптомів нервової системи є порушення почуття обсягу або почуття вібрації.
Наслідки гемолітичної анемії
гемолітична анемія є наслідком надмірного швидкого руйнування еритроцитів. Симптоми хронічного гемолізу еритроцитів і включають в себе загальні симптоми анемії. такі як слабкість, зниження толерантності до навантаження, задишка, запаморочення. Крім цього, розвивається жовтяниця, збільшується селезінка і дуже часто з'являється жовчнокам'яна хвороба.
Гостра форма проявляється високою температурою, тремтінням і непритомністю. У хворого спостерігаються симптоми жовтяниці, гіпербілірубінемії. Крім того, з'являються болі в спині, голові і в животі. Згодом доходить до гемоглобінурії з сечею кольору -Темні пива-, що вказує на гостру ниркову недостатність.